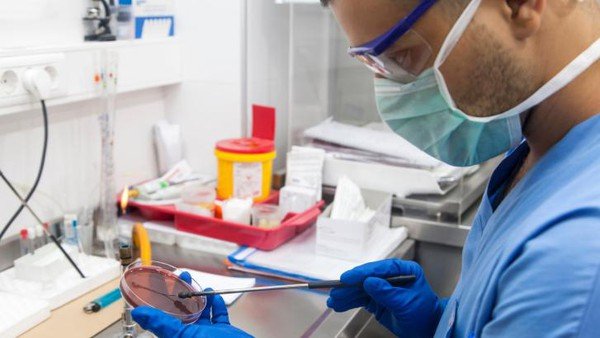

Support minnows , Date 9.8.2018 promote content on Steemit
Hello Steem friends,
I vote for 4 people who posted impressive posts every day.
The VP will be between 20%-50% on each post of the selected minnow. This is in order to promote quality and good content on Steemit.com.
What are the settings for minnow?
reputation 60 and below
-I will now check comments from my last post and upvote the best commenters posts in my opinion. please paste your -preferable post link in the comment
-The posts have to be relatively good (informative, not plagiarized , not just pictures).
-will not upvote same user post twice in a week.
List for today:
https://steemit.com/unique/@zipp/new-facts-cockroach-milk-is-rated-as-more-nutritious-than-cow-s-milk-75b4b513c7dbe
https://steemit.com/unique/@sayed-mahzar/japanese-box-watermelon-that-attracts-the-attention-of-the-world
https://steemit.com/art/@aranna/angry-art-asks-interesting-paintings
https://steemit.com/crypto/@struggle315/crypto-currencies-are-now-moving-forward
good luck!

After a long time to hold urine, there is pleasure when removing it, do you know that the pleasure we feel is very dangerous.
https://steemit.com/health/@dwiazzahra/peegasm-enjoyment-after-restraining-urine-that-turns-dangerous
The unique beauty of Crown Royal Flycatcher

https://steemit.com/unique/@andesta/the-unique-beauty-of-crown-royal-flycatcher
Congrats for all winners, here my latest post :
https://steemit.com/science/@ronggo-warsito/benefits-of-boh-thup-or-ciplukan-plants-physalis-angulata-l
Hi @yoo1900, here my latest post, I hope you want to support me
https://steemit.com/acehmacro/@tripleem/see-natural-beauty-from-different-dides
Visit to my blog pease, @yoo1900 sir
https://steemit.com/myfriday/@elshadr/2hjfqd-my-friday
You got a 10.23% upvote from @minnowvotes courtesy of @elshadr!
Thank you @yoo1900! Here is the very colorful Kadayawan Festival in Philippines!
https://steemit.com/portraitcontest/@suitcasemama/letsgoto-kadayawan-feastival-davao-city-philippines
https://steemit.com/blockchain/@struggle315/robinhood-adds-support-for-ethereum-classic

https://steemit.com/blockchain/@struggle315/robinhood-adds-support-for-ethereum-classic

this is my birthday, and goodbye last year.
https://steemit.com/life/@sweet-angel/my-birthday-4835a264161f1

marijuana plant. illicit goods. this is the link.
https://steemit.com/narural/@good-karna/two-effects-of-cannabis-plants
You got a 5.70% upvote from @oceanwhale With 35+ Bonus Upvotes courtesy of @andesta! Delegate us Steem Power & get 100%daily rewards Payout! 20 SP, 50, 75, 100, 150, 200, 300, 500,1000 or Fill in any amount of SP Earn 1.25 SBD Per 1000 SP | Discord server
Turmeric is known as one of the kitchen spices, but it is necessary to know that this turmeric has unique properties, it can smooth the skin and can also be an ingredient of herbal medicine that is very good for human health.
https://steemit.com/herbal/@efend/turmeric-is-able-to-smooth-the-skin-and-become-a-good-herbal-remedy-for-our-health
Congratulations to all winners, and hopefully I can also give the best like them.
https://steemit.com/knowledge/@soekahsoelong/apparently-the-human-body-can-do-6-extreme-things
https://steemit.com/bitcoin/@postpublication/bitcoin-weakens-again-because-of-the-inability-to-control-it

Thank you @yoo1900! Here is the very colorful Kadayawan Festival in Philippines!
https://steemit.com/portraitcontest/@suitcasemama/letsgoto-kadayawan-feastival-davao-city-philippines
https://steemit.com/fish/@recardo88/this-very-rare-fish-is-in-the-eyes-of-all-of-us

https://steemit.com/bitcoin/@steemhop/enjoy-starbucks-coffee-with-bitcoin
https://steemit.com/bitcoin/@postpublication/bitcoin-weakens-again-because-of-the-inability-to-control-it

https://steemit.com/bird/@goodhaikal/this-image-is-simple-for-you-who-see-this-post-042

https://steemit.com/blockchain/@struggle315/robinhood-adds-support-for-ethereum-classic

Hey all of you, we don't lose to this superhuman, he can be super, but on the market we have to be super.
https://steemit.com/funny/@urbas/unique-even-great-people-are-currently-trading-on-the-market-in-gital
Dear friends, want to register for the advice of doctor Shigeaki Hinohara, he is able to live at the age of 105 and hopefully we can do what he does.
https://steemit.com/health/@uncu/these-are-4-longevity-secrets-from-doctors-who-are-105-years-old
Unique creative
https://steemit.com/modification/@ardiansyah/the-longest-and-most-unique-bike
Unique dresses from nature for us, everything is not impossible and all can be done, dresses from leaves and fruit and even vegetables, unique and cool
https://steemit.com/creative/@kamariah/unique-dress-from-natural-plants
You got a 8.33% upvote from @brupvoter courtesy of @andesta!
Cocoon fish lungfish that can live in dry soil, and without any water.

https://steemit.com/amazing/@dejingkie/cocoon-fish-lungfish-that-can-live-in-dry-soil-and-without-any-water
Some Tips for Losing Weight After Age 40 for your body's health

https://steemit.com/health/@simatupang/some-tips-for-losing-weight-after-age-40
Nigerian man buries his father in a BMW X5 car for 1.2 billion.
https://steemit.com/strange/@donaltruck/nigerian-man-buries-his-father-in-a-bmw-x5-car-for-1-2-billion
First time, trial of stem cells in humans to treat Parkinson's.
https://steemit.com/health/@stonesteem83/first-time-trial-of-stem-cells-in-humans-to-treat-parkinson-s
the effects of tobacco addiction. this is my link.
https://steemit.com/life/@maxmax/different-perceptions-about-tobacco
This post has received a 4.59 % upvote from @boomerang.
https://steemit.com/fish/@recardo88/this-very-rare-fish-is-in-the-eyes-of-all-of-us

https://steemit.com/bird/@goodhaikal/this-image-is-simple-for-you-who-see-this-post-042

https://steemit.com/bitcoin/@steemhop/enjoy-starbucks-coffee-with-bitcoin

https://steemit.com/bitcoin/@postpublication/bitcoin-weakens-again-because-of-the-inability-to-control-it

https://steemit.com/blockchain/@struggle315/robinhood-adds-support-for-ethereum-classic

@yoo1900 please visit my link you might be interested.

https://steemit.com/esteem/@fadli92/three-legged-chicken-c8cf6144b2d0e
You got a 16.57% upvote from @whalecreator courtesy of @fadli92! Delegate your Steem Power to earn 100% payouts.
Creative is always interesting
https://steemit.com/creative/@codee/unique-incidentally-or-intentionally
Turmeric is known as one of the kitchen spices, but it is necessary to know that this turmeric has unique properties, it can smooth the skin and can also be an ingredient of herbal medicine that is very good for human health.
https://steemit.com/herbal/@efend/turmeric-is-able-to-smooth-the-skin-and-become-a-good-herbal-remedy-for-our-health
Dear friends, want to register for the advice of doctor Shigeaki Hinohara, he is able to live at the age of 105 and hopefully we can do what he does.
https://steemit.com/health/@uncu/these-are-4-longevity-secrets-from-doctors-who-are-105-years-old
Unique creative
https://steemit.com/modification/@ardiansyah/the-longest-and-most-unique-bike
Thank you @yoo1900! Here is the very colorful Kadayawan Festival in Philippines!
https://steemit.com/portraitcontest/@suitcasemama/letsgoto-kadayawan-feastival-davao-city-philippines
Congrats for all winners, here my latest post :
https://steemit.com/science/@ronggo-warsito/benefits-of-boh-thup-or-ciplukan-plants-physalis-angulata-l
Hi @yoo1900, here my latest post, I hope you want to support me
https://steemit.com/acehmacro/@tripleem/see-natural-beauty-from-different-dides
Please visit to my blog @yoo1900
https://steemit.com/petals/@elshadr/step-by-step-blossoming-of-wildflowers
Hey all of you, we don't lose to this superhuman, he can be super, but on the market we have to be super.
https://steemit.com/funny/@urbas/unique-even-great-people-are-currently-trading-on-the-market-in-gital
Congratulations to all winners, and hopefully I can also give the best like them.
https://steemit.com/knowledge/@soekahsoelong/apparently-the-human-body-can-do-6-extreme-things
Unique dresses from nature for us, everything is not impossible and all can be done, dresses from leaves and fruit and even vegetables, unique and cool
https://steemit.com/creative/@kamariah/unique-dress-from-natural-plants
Turmeric is known as one of the kitchen spices, but it is necessary to know that this turmeric has unique properties, it can smooth the skin and can also be an ingredient of herbal medicine that is very good for human health.
https://steemit.com/herbal/@efend/turmeric-is-able-to-smooth-the-skin-and-become-a-good-herbal-remedy-for-our-health
Something unique and interesting
https://steemit.com/entertainment/@hitler-jerman/entertainment-the-most-unique-animal-in-the-world
Dear friends, want to register for the advice of doctor Shigeaki Hinohara, he is able to live at the age of 105 and hopefully we can do what he does.
https://steemit.com/health/@uncu/these-are-4-longevity-secrets-from-doctors-who-are-105-years-old
Some Tips for Losing Weight After Age 40 hopefully useful for @yoo1900 and others

https://steemit.com/health/@simatupang/some-tips-for-losing-weight-after-age-40
The unique beauty of Crown Royal Flycatcher

https://steemit.com/unique/@andesta/the-unique-beauty-of-crown-royal-flycatcher
Helping not only fellow humans but giving help to other beings, it is a very noble act in the eyes of God.
https://steemit.com/life/@jafar/helping-is-not-only-a-fellow-human-being-but-helping-animals-is-also-a-very-noble-deed
Goldilock as a safe Digital Asset Storage Solution

https://steemit.com/originalworks/@zafar82/goldilock-as-a-digital-asset-storage-solution
In life that is difficult to get rid of is a hobby, and for example like this grandfather even though the age is advanced but he still likes cockfighting
https://steemit.com/unique/@loncoba/hobby-even-though-you-are-old-you-are-still-active
Hey all of you, we don't lose to this superhuman, he can be super, but on the market we have to be super.
https://steemit.com/funny/@urbas/unique-even-great-people-are-currently-trading-on-the-market-in-gital

Before you want to build a house, you should recommend to look and design well so that when you are ready, you will not be disappointed and the money spent is not in vain.
https://steemit.com/creative/@ersa-siregar/examples-of-comfortable-and-beautiful-homes
In our lives we do not have to always be straight when walking, but walk straight but must always be vigilant so that your life will always be peaceful and happy
https://steemit.com/inspiration/@aulians/unique-and-inspiring-traffic-signs
Congratulations to all winners, and hopefully I can also give the best like them.
https://steemit.com/knowledge/@soekahsoelong/apparently-the-human-body-can-do-6-extreme-things
Hi @yoo1900, tonight I want to show you about the uniqueness of the coconut fruit, and of course this is very rare for us to meet and hopefully you like what I share
https://steemit.com/magical/@barpatek/the-coconut-shoots-are-very-unique
Helping not only fellow humans but giving help to other beings, it is a very noble act in the eyes of God.
https://steemit.com/life/@jafar/helping-is-not-only-a-fellow-human-being-but-helping-animals-is-also-a-very-noble-deed
https://steemit.com/fish/@recardo88/this-very-rare-fish-is-in-the-eyes-of-all-of-us

https://steemit.com/bitcoin/@postpublication/bitcoin-weakens-again-because-of-the-inability-to-control-it

Something unique and interesting
https://steemit.com/entertainment/@hitler-jerman/entertainment-the-most-unique-animal-in-the-world
Hey all of you, we don't lose to this superhuman, he can be super, but on the market we have to be super.
https://steemit.com/funny/@urbas/unique-even-great-people-are-currently-trading-on-the-market-in-gital
https://steemit.com/bitcoin/@steemhop/enjoy-starbucks-coffee-with-bitcoin

Tobacco addiction, this is the link.
https://steemit.com/life/@maxmax/different-perceptions-about-tobacco
Illicit goods namely cannabis plants. partly useful. this is my link.
https://steemit.com/narural/@good-karna/two-effects-of-cannabis-plants
You've received a lifting from @botox ! Consider delegating to earn passive income 20SP,50SP,100SP,200SP.
Tu viens de recevoir un lifting de @botox ! Envisager de déléguer pour gagner un revenu passif 20SP,50SP,100SP,200SP.
Great post! You've earned a 33.49% upvote from @dolphinbot

Join the DolphinBot Team for Daily Payouts in Steem! Click here: http://bit.ly/dolphinbot
They have enlisted the help of the @alliedforces!
We gladly answer your call!
(@alliedforces is a collaboration of witnesses @jatinhota & @enginewitty)
Have you supported your favorite witnesses?
https://steemit.com/bitcoin/@postpublication/bitcoin-weakens-again-because-of-the-inability-to-control-it

Great post!
Thanks for tasting the eden!
You got a 19.75% upvote from @steembloggers courtesy of @fadli92!
I visited one of the coolest tourist parks in Indonesia. this is the link.
https://steemit.com/travel/@alizee/one-of-the-interesting-tourist-parks-in-indonesia
What they do (sparrows), we can take the essence. this is my link.
https://steemit.com/science/@blogtrades/fair-and-keep-trying
Before you want to build a house, you should recommend to look and design well so that when you are ready, you will not be disappointed and the money spent is not in vain.
https://steemit.com/creative/@ersa-siregar/examples-of-comfortable-and-beautiful-homes
Helping not only fellow humans but giving help to other beings, it is a very noble act in the eyes of God.
https://steemit.com/life/@jafar/helping-is-not-only-a-fellow-human-being-but-helping-animals-is-also-a-very-noble-deed
The influence of tobacco to addiction. this is my link.
https://steemit.com/life/@maxmax/different-perceptions-about-tobacco
The story of the old widow. this is my new link
https://steemit.com/life/@m-16/the-story-of-a-grandmother-old-widow
In our lives we do not have to always be straight when walking, but walk straight but must always be vigilant so that your life will always be peaceful and happy
https://steemit.com/inspiration/@aulians/unique-and-inspiring-traffic-signs
https://steemit.com/science/@ronggo-warsito/benefits-of-boh-thup-or-ciplukan-plants-physalis-angulata-l
https://steemit.com/bitcoin/@steemhop/enjoy-starbucks-coffee-with-bitcoin

Congratulations to all winners, and hopefully I can also give the best like them.
https://steemit.com/knowledge/@soekahsoelong/apparently-the-human-body-can-do-6-extreme-things
https://steemit.com/fish/@recardo88/this-very-rare-fish-is-in-the-eyes-of-all-of-us
https://steemit.com/bird/@goodhaikal/this-image-is-simple-for-you-who-see-this-post-042

Hi @yoo1900, tonight I want to show you about the uniqueness of the coconut fruit, and of course this is very rare for us to meet and hopefully you like what I share
https://steemit.com/magical/@barpatek/the-coconut-shoots-are-very-unique
https://steemit.com/strange/@donaltruck/nigerian-man-buries-his-father-in-a-bmw-x5-car-for-1-2-billion

Nigerian man buries his father in a BMW X5 car for 1.2 billion.
In life that is difficult to get rid of is a hobby, and for example like this grandfather even though the age is advanced but he still likes cockfighting
https://steemit.com/unique/@loncoba/hobby-even-though-you-are-old-you-are-still-active
Congratulations to all winners,
And hopefully always be the best
https://steemit.com/modification/@ardiansyah/the-longest-and-most-unique-bike
https://steemit.com/bird/@goodhaikal/this-image-is-simple-for-you-who-see-this-post-042

Congrats to all the fellow Steemit winners, Steem on and keep up the good work. Thank you @yoo1900 you have been a blessing for me. Here is a eBay auction Item I didn't win and thought I'd share because its a Cryptocurrency Baseball card that I really wanted but got outbid, enjoy and God Bless.....
https://steemit.com/cryptocurrency/@shoemanchu/have-you-every-wanted-something-so-bad-on-ebay-and-got-outbid
Benefits fruit kedondong for body
https://steemit.com/fruit/@adimantong/benefits-of-kedondong-fruit-for-body-health-eafb7174ba275
Creative is always interesting
https://steemit.com/creative/@codee/unique-incidentally-or-intentionally
Congratulations for those who have been chosen as winners:

Hello @yoo1900,Peegasm, Enjoyment After Restraining Urine That Turns Dangerous.
https://steemit.com/health/@dwiazzahra/peegasm-enjoyment-after-restraining-urine-that-turns-dangerous
Hi @yoo1900, one of the fish that can survive in dry land, without water.
https://steemit.com/amazing/@dejingkie/cocoon-fish-lungfish-that-can-live-in-dry-soil-and-without-any-water

Unique dresses from nature for us, everything is not impossible and all can be done, dresses from leaves and fruit and even vegetables, unique and cool
https://steemit.com/creative/@kamariah/unique-dress-from-natural-plants
Nigerian man buries his father in a BMW X5 car for 1.2 billion.
https://steemit.com/strange/@donaltruck/nigerian-man-buries-his-father-in-a-bmw-x5-car-for-1-2-billion
Something unique and impossible but this is there
https://steemit.com/impossible/@ocian/there-is-something-unique-and-strange-in-this-picture
congratulations to the winners. I will put it back. this is my link about creative.
https://steemit.com/art/@aranna/angry-art-asks-interesting-paintings
Turmeric is known as one of the kitchen spices, but it is necessary to know that this turmeric has unique properties, it can smooth the skin and can also be an ingredient of herbal medicine that is very good for human health.
https://steemit.com/herbal/@efend/turmeric-is-able-to-smooth-the-skin-and-become-a-good-herbal-remedy-for-our-health
Hello @yoo1900,Peegasm, Enjoyment After Restraining Urine That Turns Dangerous.
https://steemit.com/health/@dwiazzahra/peegasm-enjoyment-after-restraining-urine-that-turns-dangerous
Dear friends, want to register for the advice of doctor Shigeaki Hinohara, he is able to live at the age of 105 and hopefully we can do what he does.
https://steemit.com/health/@uncu/these-are-4-longevity-secrets-from-doctors-who-are-105-years-old
Helping not only fellow humans but giving help to other beings, it is a very noble act in the eyes of God.
https://steemit.com/life/@jafar/helping-is-not-only-a-fellow-human-being-but-helping-animals-is-also-a-very-noble-deed
Dear friends, want to register for the advice of doctor Shigeaki Hinohara, he is able to live at the age of 105 and hopefully we can do what he does.
https://steemit.com/health/@uncu/these-are-4-longevity-secrets-from-doctors-who-are-105-years-old
hi @yoo1900 Thank You & Have a Great Day
https://steemit.com/colorchallenge/@ramialbanna/village-in-belgium